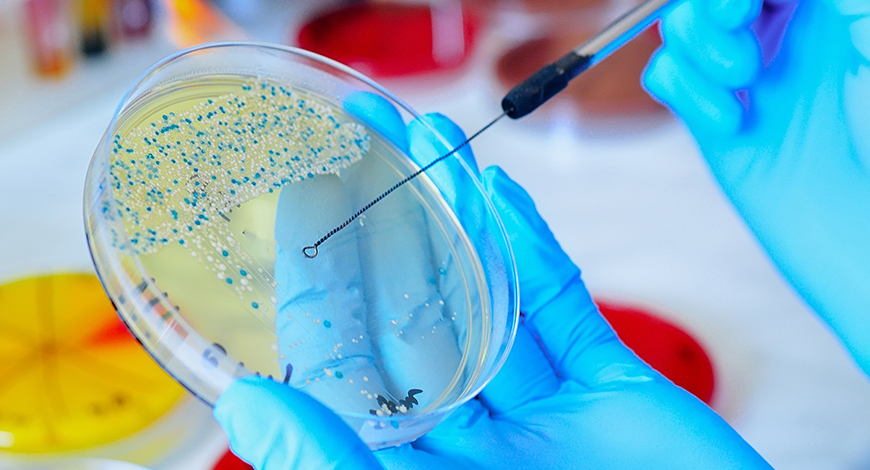

Radiodiagnosis
Our department has a long tradition of excellence in both diagnostic and educational activities. We are guided by the mission to maintain excellence in education, research and service.

Pathology
The Department of Pathology provides comprehensive diagnostic services with an emphasis on ensuring the quality of services including turn-around-time thereby helping the clinicians
Microbiology
The department consists of highly developed entry restricted Mycobacteriology Lab having the accreditation for U-DST for MTB (under NTEP program of government of India).

ENT, Head & Neck surgery
The department has a well & equippedaudiology and neuro-otology to lab carrying out various investigations like pure tone audiometry, impedance audiometry etc.

Neuro-Physiology Lab
Our team of dedicated neurologists, neurosurgeons, and medical professionals is committed to providing comprehensive care.
Biochemistry
The Department is engaged in teaching of undergraduate and postgraduate students with a vast curriculum. Understanding the molecular basis of life.

Gynaecology
The Department of Obstetrics and Gynecology at SRMS Hospital—an integral part the institution since its inception, offers spectrum of world-class and comprehensive health care services

Non Invasive Lab
The Department of Cardiology boasts of a faculty that is nationally and internationally recognized in treating various cardiovascular conditions including atrial fibrillation

Gastroenterology
The Gastroenterology department made its beginnings with the acquisition of equipment related to performing diagnostic and therapeutic Video Upper GI Endoscopy and Colonoscopy.
Respiratory Medicine
Welcome to the Respiratory Medicine Department at SRMS Hospital in Bareilly. Our commitment to providing exceptional healthcare services is reflected in our state-of-the-art facilities.
Ophthalmology
One of the first-borns of the Institute of Medical Sciences, founded in 2002, by Shri Ram Murti Smarak (SRMS) Trust, amidst scenic green pollution-free environs.

Gastroenterology
The Gastroenterology department made its beginnings with the acquisition of equipment related to performing diagnostic and therapeutic Video Upper GI Endoscopy and Colonoscopy.
Psychiatry
The depression hospital in Bareilly has a fully functional department of psychiatry with facilities for indoor and outpatient treatment of behavioral problems of adults and children.

Urology
At SRMS Hospital in Bareilly, we are committed to providing comprehensive and state-of-the-art urology services and facilities to address a wide range of urological conditions.



